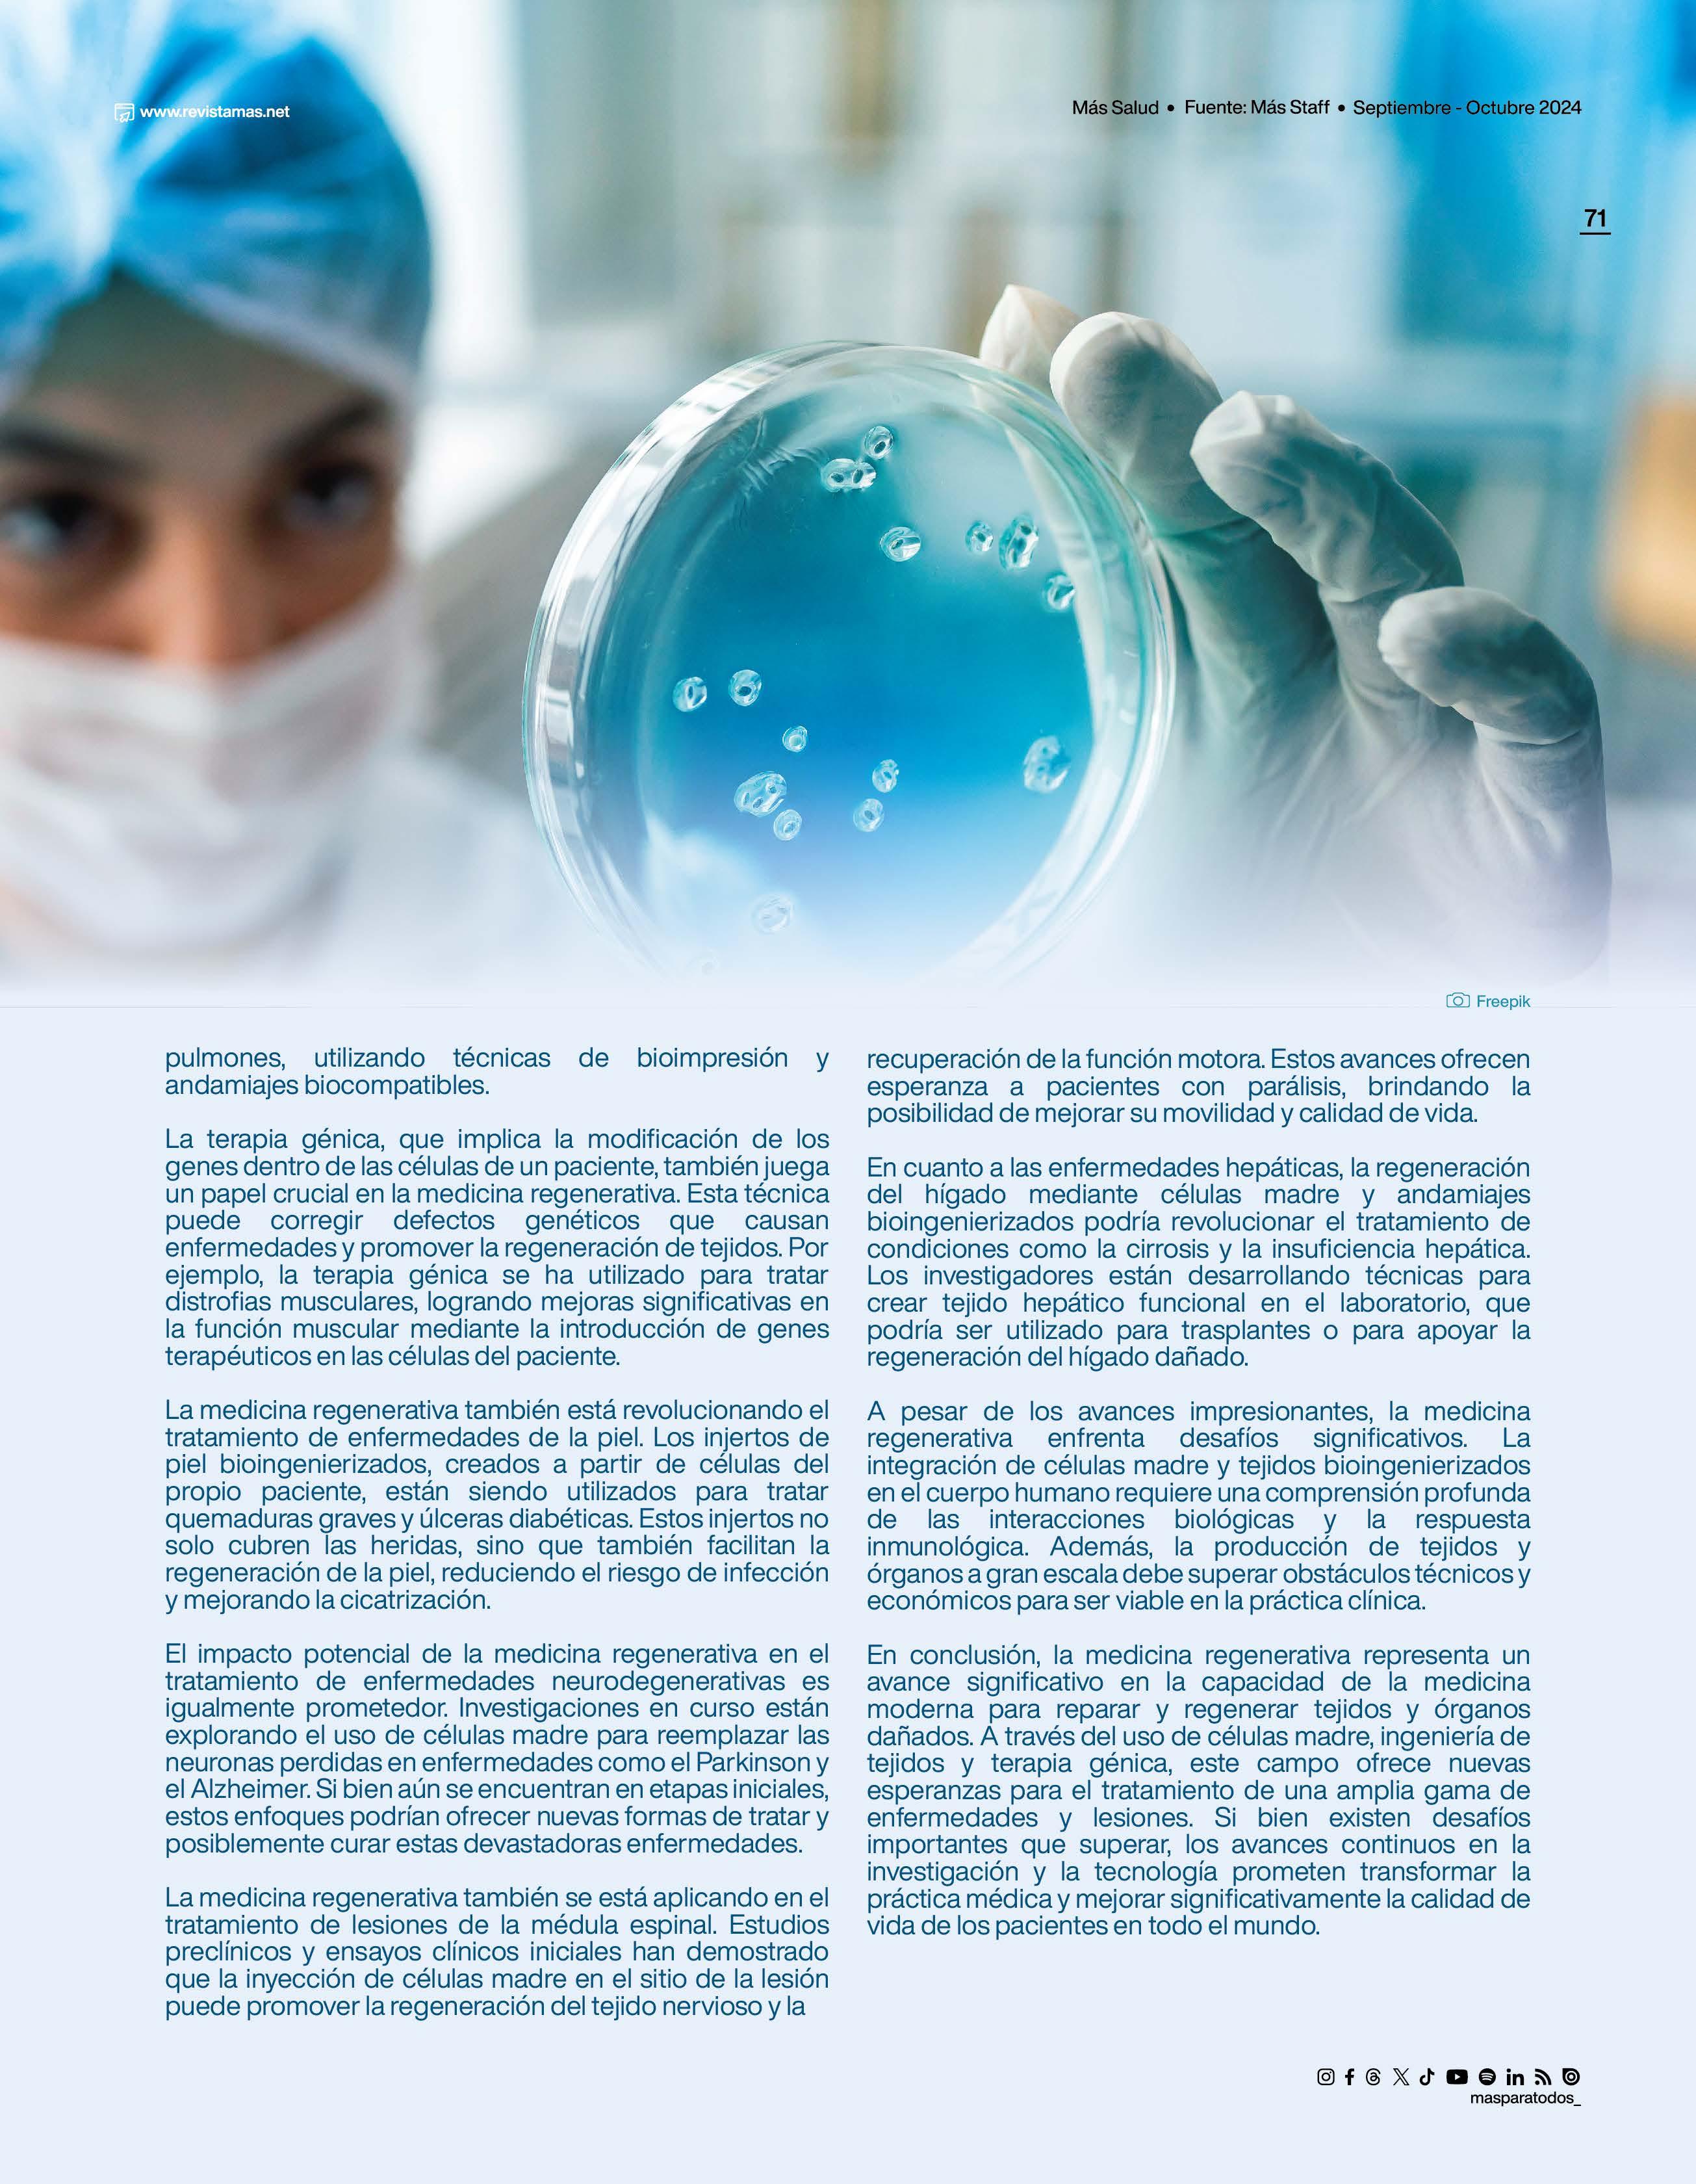

Presentamos con orgullo la cuarta edición de la Revista Más para Todos, centrada en “SALUD E INNOVACIÓN BIOMÉDICA” en Panamá.
En esta edición, exploramos cómo Panamá se ha convertido en un referente en salud e innovación biomédica en la región. Gracias a la colaboración entre instituciones académicas, centros de investigación y hospitales, el país ha logrado avances significativos en enfermedades tropicales como el dengue, la malaria y la leptospirosis.
Destacamos la integración de tecnologías como la telemedicina, la inteligencia artificial y la genómica, que han mejorado la atención sanitaria, aumentando la eficiencia y calidad del sistema de salud.
Además, resaltamos la formación de profesionales en áreas de vanguardia y la promoción de la investigación científica, consolidando a Panamá como líder en el desarrollo de soluciones innovadoras.
Te invitamos a descubrir cómo estos avances están trazando un nuevo camino hacia un futuro más saludable y tecnológico para todos.